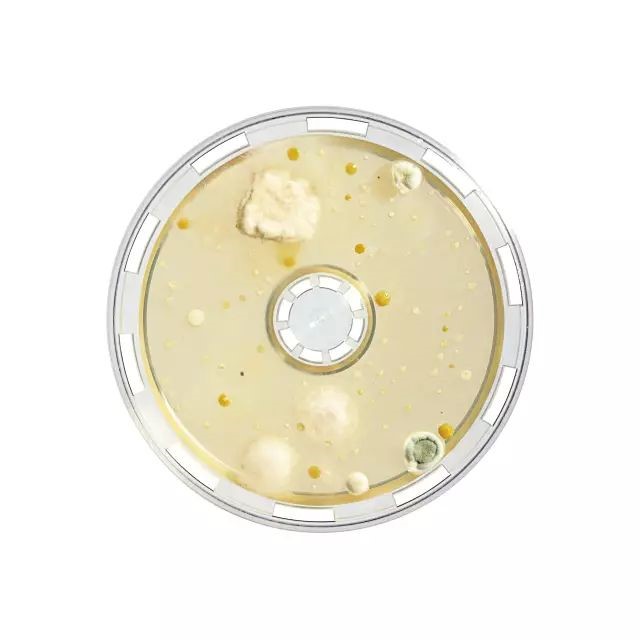
产品细节图片4

相关产品推荐更多 >
万千商家帮你免费找货
0 人在求购买到急需产品
- 详细信息
- 询价记录
- 文献和实验
- 技术资料
病毒采样器/浮游菌采样器 TIPS800
目前,随着生物科技的发展,病毒的种类也在不断更新,一系列新型病毒通过空气等媒介快速传播,可引起人类及动物的多种严重疾病。
由于病毒是一类不具细胞结构,具有遗传、复制等生命特征的微生物,其大小小于细菌,故空气中的病毒采集难度大于细菌,采集过程中的截留率也值得关注。
帝博思提供一种适用于截留病毒的产品(TIPS800),为检测环境中的病毒提供多种解决方案。
水溶膜是一种采用明胶制成的滤膜,可溶于水。标称孔径3μm,区别于普通的3μm滤膜,水溶膜厚度为250μm,是普通纤维素类滤膜的两倍以上,电镜下可见疏松多孔结构,属于深层过滤,可以有效截留粒径较小的微生物。经检测,对T3病毒具有99.94%的截留率。

电子显微镜下的水溶膜照片
使用便携式病毒采样器/浮游菌采样器 TIPS800,搭配单层无菌包装水溶膜采样头,通过设置合适的流速与采样体积,对空气中的病毒进行截留。采样结束后使用缓冲液溶解水溶膜,收集样品中的病毒,并进行下一步处理。

您是否也有这样的烦恼?
● 难以寻找到合适的病毒采集方法
● 截留病毒后处理步骤复杂
● 对设备的病毒截留率表示怀疑
● 寻求轻便易携带的装置进行采样
对比
| 传统采集方法 |
水溶膜采集方法
|
| 回收率低 |
高回收率
|
| 采集后处理步骤复杂 |
采样后可直接将凝胶膜溶解
|
| 采样前的清洁及消毒过程存在风险 |
无菌包装,一次性耗材,无二次污染风险
|
水溶膜基于其独特的材质与结构,对微生物具有高截留率,并且水溶膜的含水性有利于维持所收集微生物的存活,从而提供长达8小时的连续采样时间。

水溶膜在全球诸多领域都得到成功的应用,包括了:在流感爆发时期,进行流感病毒采样与检测;在航空航天领域进行特殊区域的空气采样;在雾霾等极端空气环境下进行病毒采样与分析;在养殖厂进行特殊致病菌的采样…...
| 水溶膜特点 |
标称孔径3μm,直径80mm,厚度250μm,属于深层过滤 |
| 耐热 |
最高 60°C |
| 空气流量 |
Approx. 2.7 l/min./cm2 at ΔP = 0.05 bar |
| 细菌和病毒截留率 |
1. 0.25m/s入口速度,Bac.sub.niger.spores,截留率为99.9995%, 2. 80%相对湿度和0.3m/s入口速度下,T3病毒截留率为99.94% |
| 过滤面积 |
38.5 cm2 |
| 工作环境要求 |
最高温度30°C,最大相对湿度85% |
| 灭菌方式 |
Gamma 射线灭菌 |
经验证水溶膜可有效截留病毒,保证采样效率及成功率。
水溶膜使样品的后处理方式选择性更多,可以满足不同领域对于检测空气中病毒的应用需求。
多种无菌包装的水溶膜可供选择,无二次污染风险,应用方式灵活。
便携式可充电采样器,适用于不同环境情况。
配置
便携式病毒采样器/浮游菌采样器主机(TIPS800) + 单层无菌包装水溶膜采样头(TIPS800-10)

风险提示:丁香通仅作为第三方平台,为商家信息发布提供平台空间。用户咨询产品时请注意保护个人信息及财产安全,合理判断,谨慎选购商品,商家和用户对交易行为负责。对于医疗器械类产品,请先查证核实企业经营资质和医疗器械产品注册证情况。
- 作者
- 内容
- 询问日期
文献和实验其背部皮肤和尾部,腹部向上,头呈低位。 ❹ 一手持注射器,另一手抓紧背部皮肤使腹部皮肤紧绷,在小鼠两大腿根连线与腹中线交叉点一侧约0.3-0.5cm位置(偏左/偏右)刺入皮下。 ❺ 针头到达皮下后,沿皮下向前推进2-3cm,然后注射器针头与皮肤呈45°角刺入腹膜,慢慢感觉到抵抗力消失,即可快速推注病毒液体。 ❻ 注射完毕后,轻轻将针头旋转一定角度,缓慢拔出针头,防止液体外漏,切记快进针、缓出针。 ※ 注意:靠近胰腺处进行腹腔注射效果更佳哦!
(一)免疫(immunity) 传统概念:指机体对病原体的感染有抵抗力。 现代概念:机体免疫系统识别「自己」和「非己」,对自身成分产生天然免疫耐受,对非己异物产生排除的一种生理反应。 免疫系统的功能: 1. 免疫防御:识别、清除入侵的病原体及有害生物分子。 2. 免疫监视:识别、清除体内突变细胞和病毒感染细胞。 3. 免疫自稳:清除体内衰老、损伤或变易性细胞,对自身成分耐受,维持内外环境相对稳定。 免疫的分类 根据种系
1、目的SYSMEXAUTOMATEDMEMATOLOGYANALYZER(XS800i)血细胞分析仪是用于测血细胞(红细胞、白细胞和血小板)数量和白细胞分类的仪器。测血液中血细胞数量的变化对临床有关疾病的诊断、观察疾病的变化及治疗效果具有重要参考价值。2、原理2.1XS800i采用一束半导体激光照射标本,并依据每个细胞产生的三种信号来相互区分,即前向散射光,侧向射散光和侧向光和侧向荧光。前向散射光反映细胞体积,侧向散射光反映细胞内涵物,如核和颗粒,侧向荧光反映细胞脱氧核糖核酸(DNA)和核糖
技术资料暂无技术资料 索取技术资料










